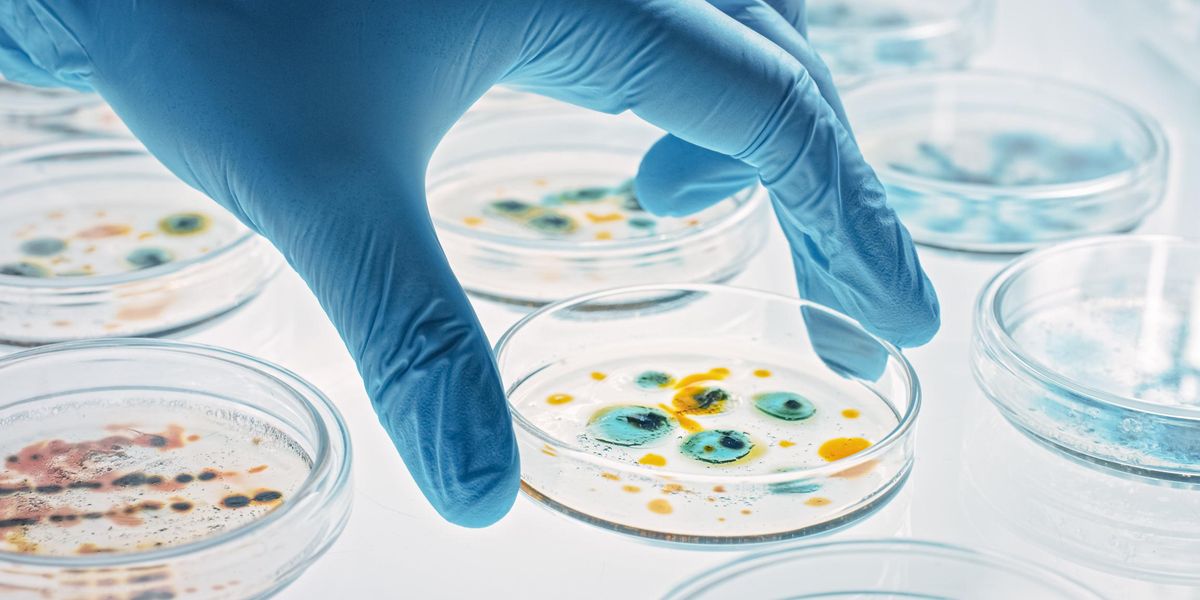

Just because Fauci and the goose-stepping, parroting leftists say children need to wear masks does not make that a good idea. Not at all.
www.theblaze.com
In a press release obtained by TheBlaze and posted at RationalGround.com, six Alachua County, Florida, parents reported the findings of the lab cultures of their children's masks worn in school. The parents sent the six masks to the University of Florida's Mass Spectrometry Research and Education Center after they were worn for five to eight hours, most during in-person schooling by children ages 6 through 11. Although many students across the country likely wore dirty masks indefinitely for numerous days, the face masks studied in this analysis were new or freshly laundered before wearing. One of the masks submitted was from an adult who wore it at work as a cosmetologist.
The resulting report found that five masks were contaminated with bacteria, parasites, and fungi, including three with dangerous pathogenic and pneumonia-causing bacteria.
The lab used a method called proteomics to extract proteins from the masks and sequence them. The analysis detected the following 11 alarmingly dangerous pathogens on the masks:
Horowitz: A group of Florida parents cultured their children’s masks and found dangerous bacteria | Blaze Media
The idea of children, including preschoolers, walking around with bacteria traps on their breathing orifices all day so shocked the conscience that last summer, a bunch of internet parodies were produced illustrating such absurdity. Then, within weeks, most local governments mandated this cruel...

The resulting report found that five masks were contaminated with bacteria, parasites, and fungi, including three with dangerous pathogenic and pneumonia-causing bacteria.
The lab used a method called proteomics to extract proteins from the masks and sequence them. The analysis detected the following 11 alarmingly dangerous pathogens on the masks: